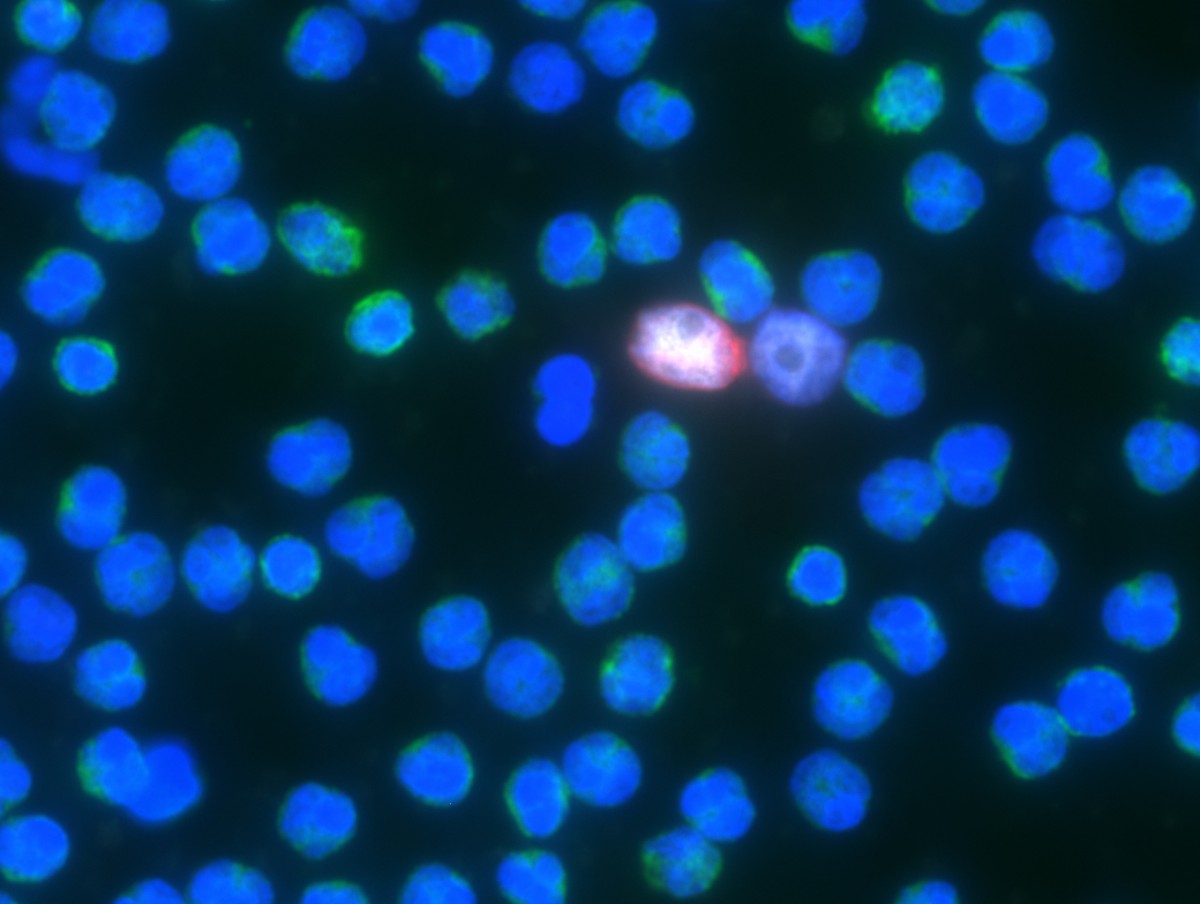

Print
04 February 2016
Elaine Schattner / Forbes
Last week, the FDA gave breakthrough status to a drug, Lynparza (olaparib, AstraZeneca), for treating some forms of metastatic prostate cancer. This means the agency will expedite review and possible approval of this new kind of therapy, a PARP inhibitor for men with advanced, refractory prostate cancer.
Until recently, men with prostate cancer that spreads after surgical or chemical “castration,” or androgen deprivation therapy, had few options. Since 2012, the FDA has approved several agents including two innovative hormone modulators, Xtandi and Zytiga. Now, based on science and drugs in the pipeline, men with metastatic prostate cancer can expect to live longer. They and their oncologists will face a growing array of treatment choices.
The idea of a liquid biopsy is to evaluate malignant bits, cells, DNA or other material in an ordinary blood sample. The concept has been floating for a long time, and is feasible now. But apart from the research setting, few of these tests have entered clinics. None are FDA approved (yet).
What’s advantageous about a liquid biopsy–if it’s accurate–is that checking for cancer in blood is a lot easier, less risky and (maybe) less costly than undergoing a biopsy of, say, a malignant spot in the liver or lung or bone. From a laboratory doctor’s perspective, though, analyzing rare malignant cells in blood, cell-free DNA and other tumor bits can be tricky.
In 2016, several types of liquid biopsy tests are in the works, with two broad types nearing clinical readiness: Examination of genetic material (cell-free DNA or circulating tumor DNA, which are not quite the same) and of circulating tumor cells (CTCs).
Circulating tumor cells refer to malignant cells that have broken off from a tumor–like breast, kidney, lung, ovarian, pancreatic, prostate and other “solid” cancers–and entered the bloodstream, where they may be very rare and hard to spot, no less to capture and analyze. If found, CTCs provide a window into a cancer’s growth, as its genetic, protein and other cellular aspects change over time within an individual, and vary.
A few months ago, I met with Murali Prahalad, CEO of Epic Sciences (San Diego). We discussed the company’s methods of processing blood samples to store, identify and examine circulating tumor cells (CTCs). Since then I’ve been following reports on Epic’s method and other, competing CTC platforms.
What distinguishes Epic Sciences’ method is, chiefly, the way it captures and processes CTCs. Most other systems “pull out” CTCs from blood samples using specific antibodies, affixed to a microfluidic chip or a magnetic bead, or based on the cells’ size.
A CTC positive for the androgen receptor (image courtesy of Epic Sciences, San Diego)
“There’s such a diversity of protein expression, and size of cancer cells,” Prahalad considered. Selecting cells based on their having particular molecules at the surface, or by their largeness, would eliminate small, dying or unexpected CTCs from analysis.
“Our system works like molecular Velcro,” Prahalad told me. “We capture everything.”
Typically, the Epic Sciences lab receives the samples within 48 to 72 hours. The small (10 ml) tube contains a standard chemical, EDTA, to avoid clotting, and a fixative. Red blood cells are removed (lysed), and the white cell layer, or “buffy coat”–the part of blood that contains all nucleated cells, including healthy white blood cells and CTCs–is prepared for analysis.
Technicians distribute the purified cells–of all sizes–onto special microscope slides where they stick, ready for evaluation. Each slide holds around 3 million cells, the yield from less than 1 ml (milliliter) of blood. From a 10 ml (2 teaspoon-sized) sample of blood, the company winds up with 36 million cells, on average. “We usually get 10 or 12 slides from each sample. Some of those are extra. We store those, as they may be needed for additional studies,” Prahalad said.
“Our proprietary scanner goes over all 3 million cells on each slide in less than 15 minutes,” Prahalad said. “The turnaround is fast.” The system uses a stain called DAPI, to check for intact nuclei, and special antibodies to mark white blood cells and a few other cell types. The scanner can simultaneously process signals from four or five colors, so that multiple stains, such as for the androgen receptor, cell surface proteins and other molecules, can be “read” simultaneously, he explained.
When death occurs from prostate cancer, it’s almost always due to metastatic disease. When prostate cancer spreads, it typically goes to bone, where it can cause fractures and pain. It can go to other organs including the liver, lungs, adrenal glands and brain. Caught early, and by contrast, prostate cancer carries an excellent prognosis; over 98% survive for 5 years, or longer.
As people with metastatic disease survive longer on medications, having real-time data about each patient’s tumor is crucial. As oncologists now appreciate, cancers tend to acquire new mutations “naturally,” and also in response to treatment; they evolve over time, within patients. So a biopsy taken from a metastatic cancer patient last year may not offer molecular information needed to direct optimal therapy this year.
“The CTCs are easy to identify from solid tumors like breast cancer, prostate cancer and small cell lung cancer,” Prahalad said. “And we can see what’s inside of them.”
“Cell-free liquid biopsy is a useful tool, but doesn’t provide all the information that would benefit patients,” Prahalad said in a recent phone discussion. “For instance, we can stain for the androgen receptor in a metastatic prostate cancer cell,” he said. “We can see if the androgen receptor is located inside of the nucleus, or if the receptor has shifted to the cytosol after a medication change,” he added.
“This kind of detailed information cannot be obtained from cell-free DNA and most other liquid biopsy systems.”
“After scanning and obtaining an image of each slide, every cell gets two coordinates,” Prahalad explained at our earlier meeting. “We worked with hematopathologists to develop our system, so we can locate any cell of interest and analyze it further.”
“Once we identify the CTCs, we can do interesting things,” Prahalad said. “We can pop the cover slip and add a FISH probe” (for cytogenetics). “We can stain for other molecules, like surface receptors or enzymes.” Using a semi-automated system, a microcapillary tube can reach any particular cell’s location, to pluck out that cell from the slide for analysis of its DNA.
“With our platform, we can evaluate any circulating tumor cell for genetic changes,” Prahalad said. “By looking at genetic material taken from individual cells from a spreading tumor, we get a different type of information that reflects the heterogeneous nature of real tumors,” he emphasized.
“We don’t look at averages or floating DNA,” he said. “We look at the individual cells from patients’ blood in real time, and interrogate specific pathway points. This way, we can rationally assign cancer drugs,” he said. “I don’t see this as happening tomorrow, but oncology has to move in this direction.”
For a 2015 report on PTEN changes and genetic drift in resistant cases of advanced prostate cancer, published in the British Journal of Cancer, investigators used the Epic CTC platform in their analyses.
Last month at a symposium in San Francisco, researchers led by Howard Scher of Memorial Sloan Kettering Hospital, in collaboration with Epic Sciences, presented new findings on highly atypical CTC forms in patients with advanced metastatic prostate cancer.
“CTC-based diagnostics are ready for prime time,” Prahalad said last fall. “We’re carrying out molecular analyses, with clonal resolution and assessment of protein, FISH and NGS, gaining insights that were not possible before from malignant cells in blood samples.
Epic Sciences has approximately 90 employees, Prahalad indicated. The San Diego lab is CLIA and CAP-certified for certain assays. The company has a partnership with LabCorp LH +0.00%, so that it can receive samples from sites in Europe and Asia, where technicians are trained to prepare the slides.
“We expect to launch our first laboratory developed test (LDT) to guide therapy selection within the first half of this year,” he told me by phone recently. Since Epic Sciences’ inception in 2008, the bulk of testing has been in metastatic prostate cancer. The company has collaborative projects ongoing, with academic centers and numerous pharmaceutical partners, involving 12 cancer types including breast cancer, melanoma and lung cancer.
Outside of clinical trials and collaborative studies with pharmaceutical companies, Prahalad expects the price of an Epic Sciences CTC assay to fall between $2,000 and $2,500. “This is a reasonable range, based on the nature of the clinical decisions we can impact as well as the savings we can accrue to payers per patient tested by getting the right patients on the right drugs,” he wrote by email.
The company has analyzed CTCs in approximately 5,000 blood samples from cancer patients. Most of those come through clinical trials and translational research projects. “We have another 15,000 samples committed to be analyzed across 60 clinical trials of all phases in 12 different cancer types,” Prahalad wrote in a recent email.
The RMI group has completed sertain projects
The RMI Group has exited from the capital of portfolio companies:
Marinus Pharmaceuticals, Inc.,
Syndax Pharmaceuticals, Inc.,
Atea Pharmaceuticals, Inc.